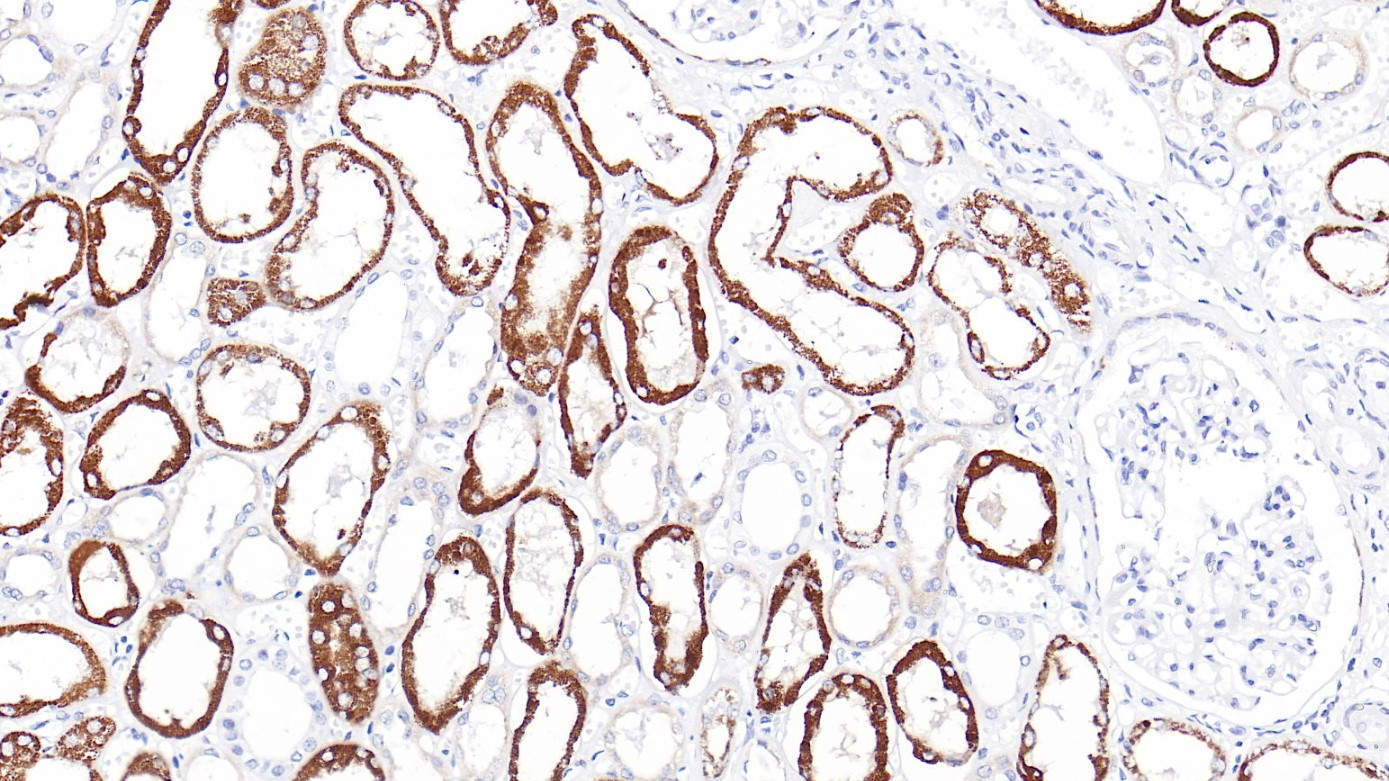
肾AMACR(CMA158)染色

产品中心

前列腺癌 AMACR(CMA158)染色
肾AMACR(CMA158)染色
AMACR/p504s 鼠单克隆抗体
AMACR/p504s是脂肪酸支链β氧化酶中的重要酶。AMACR在前列腺腺癌中高表达,而在良性前列腺组织则不表达。 AMACR的表达也可检测前列腺癌前病变,如:前列腺上皮内肿瘤(PIN)和非典型腺瘤增生。AMACR作为阳性标记连同作为阴性标记的基底细胞(34bE12/P63)一起染色,有助于确症PIN和前列腺癌小病灶。
Specifications
- 产品注册名称
- AMACR/p504s抗体试剂(免疫组织化学)
- 目录号
- I1194
- 克隆号
- CMA158
- 亚细胞定位
- 细胞质
- 阳性对照
- 肝
- 修复方式
- HIER
- 组织类型
- FFPE
- 规格
- 浓缩液:0.1mL/1mL
工作液:1.5mL/7mL
- 用途
- NMPA IVD
Applicable platform
- Biolynx平台
- Leica平台
- Roche平台
- Dako平台


